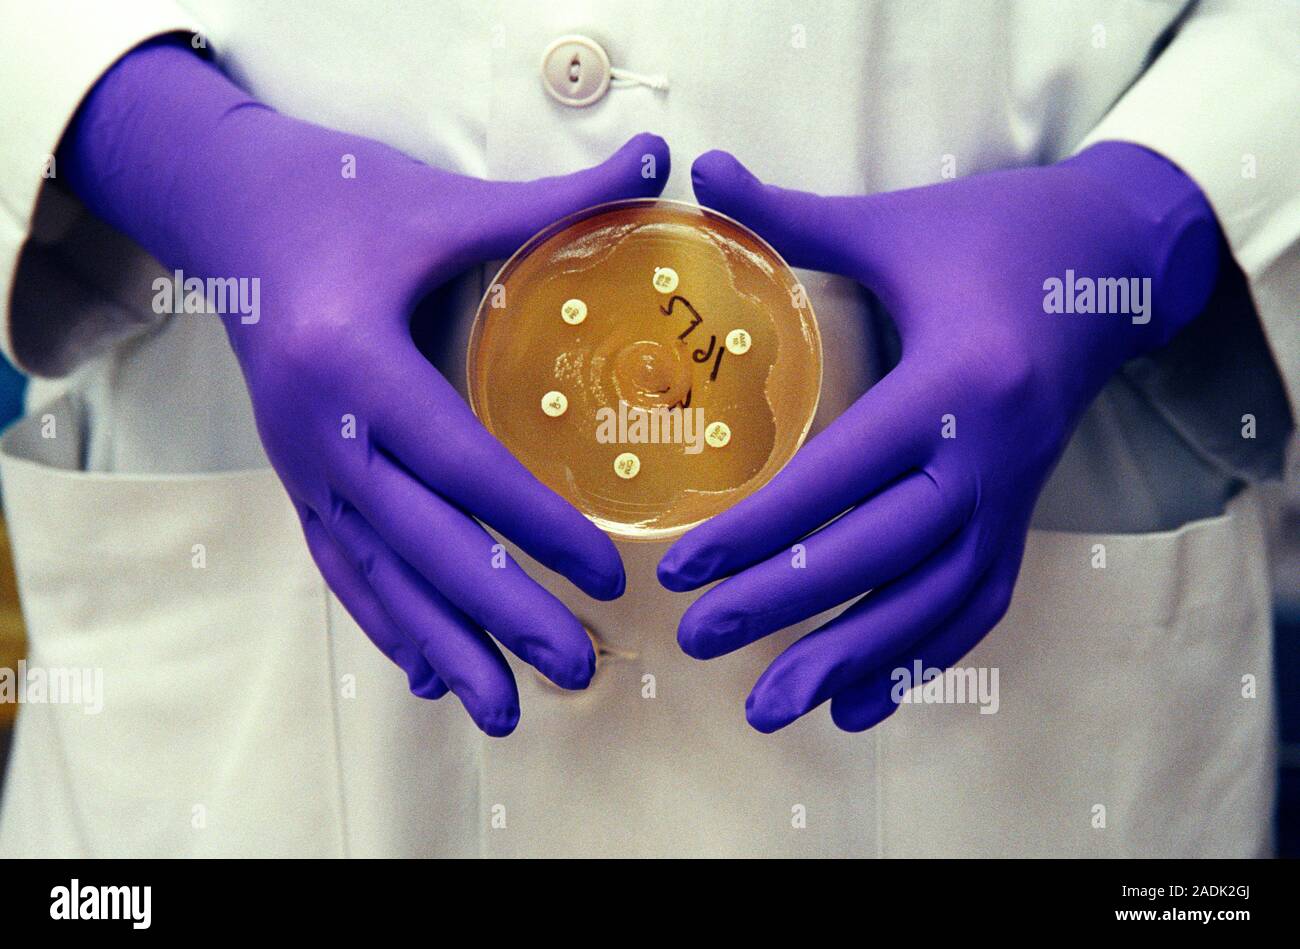

Testing the handmade khun size xl
Оранжевая обводка
Нужные продукты при беременности
Аппликация тема зайчик
Hilti 75
Рус яз 6 класс стр 5
Саленблоки переднего рычага фокус 2
Результаты олимпийских игр 2022 фигурное катание
Система вентиляции для ресторана
Кочарян ашхен аветисовна
Путь 30 трамвая
Injection reiniger effectiv
Мод на ладу 2115
Кулачек построение
Testing the handmade khun size xl 115 фотографий